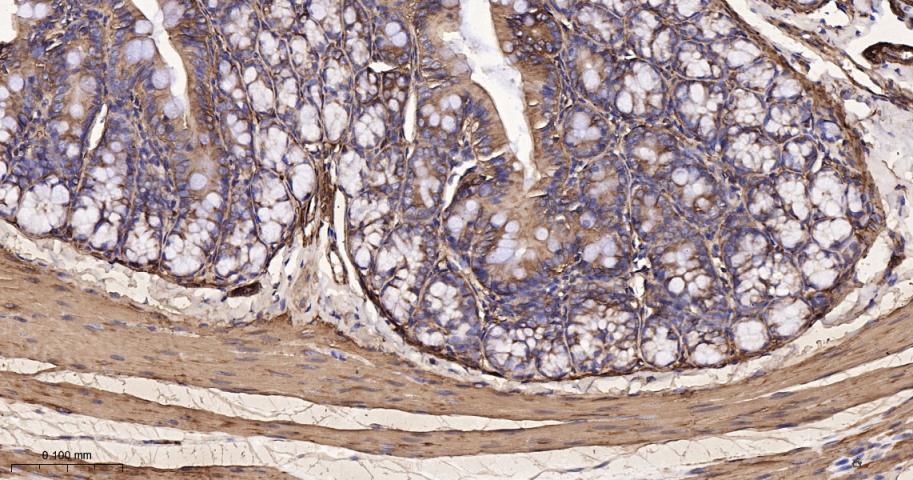
肌球蛋白调节轻链12B重组兔单抗

肌球蛋白调节轻链12B重组兔单抗
Rrmab?兔单抗

货号:bsm-62539R
产品详情
相关标记
相关产品
相关文献
常见问题
概述
产品编号
bsm-62539R
产品类型
重组兔单抗、mIHC精品抗体
英文名称
MYL12B Recombinant Rabbit mAb
中文名称
肌球蛋白调节轻链12B重组兔单抗
英文别名
MRLC2; MLC-B; 1500001M02Rik; Mylc2b; RLC-B; Mrlcb; ML12B_BOVIN; MYL12B; Myosin regulatory light chain 2-B, smooth muscle isoform; Myosin regulatory light chain 20 kDa (MLC20); Myosin regulatory light chain MRLC2; ML12B_HUMAN; MLC-2A (MLC-2); SHUJUN-1; ML12B_MOUSE; ML12B_RAT; Myosin RLC-B; Myosin regulatory light chain 2-B, smooth muscle isoform (MLC-2);
抗体来源
Rabbit
免疫原
A synthesized peptide derived from human Myosin light chain 12B: 150-172
亚型
IgG
性状
Liquid
纯化方法
affinity purified by Protein A
克隆类型
Recombinant
克隆号
12A12
理论分子量
20 kDa
检测分子量
18 kDa
储存液
10mM phosphate buffered saline(pH 7.4) with 150mM sodium chloride, 0.05% BSA, 0.02% Proclin300 and 50% glycerol.
SWISS
Gene ID
保存条件
Store at 4℃ for short term. Store at -20℃ for long term. Avoid repeated freeze/thaw cycles.
注意事项
This product as supplied is intended for research use only, not for use in human, therapeutic or diagnostic applications.
数据库链接
背景资料
Myosin regulatory subunit that plays an important role in regulation of both smooth muscle and nonmuscle cell contractile activity via its phosphorylation. Phosphorylation triggers actin polymerization in vascular smooth muscle. Implicated in cytokinesis, receptor capping, and cell locomotion.

产品应用
| 应用 | 已检合格种属 | 预测种属 | 推荐稀释比例 |
|---|---|---|---|
| WB | Human, Mouse, Rat | 1:500-2000 | |
| IHC-P | Human, Mouse, Rat | 1:100-500 | |
| IHC-F | Human, Mouse, Rat | 1:100-500 | |
| IF | Human, Mouse, Rat | 1:100-500 | |
| ICC/IF | Human, Mouse, Rat | 1:50-200 |
交叉反应
交叉反应: Human, Mouse, Rat
相关产品
暂无相关产品
靶标
基因名
MYL12B
蛋白名
Myosin regulatory light chain 12B
组织特异性
Ubiquitously expressed in various hematopoietic cells.
翻译后修饰
Phosphorylation increases the actin-activated myosin ATPase activity and thereby regulates the contractile activity. It is required to generate the driving force in the migration of the cells but not necessary for localization of myosin-2 at the leading edge. Phosphorylation is reduced following epigallocatechin-3-O-gallate treatment.
相似性
Contains 3 EF-hand domains.
功能
Myosin regulatory subunit that plays an important role in regulation of both smooth muscle and nonmuscle cell contractile activity via its phosphorylation. Phosphorylation triggers actin polymerization in vascular smooth muscle. Implicated in cytokinesis, receptor capping, and cell locomotion.
标记抗体
暂无标记数据
同靶标产品
暂无同靶标产品
相关文献
提示: 发表研究结果有使用 bsm-62539R 时请让我们知道,以便我们可以引用参考文章。作为回馈,资料提供者将获得我们送上的小礼品。
暂无相关文献
常见问题
暂无常见问题